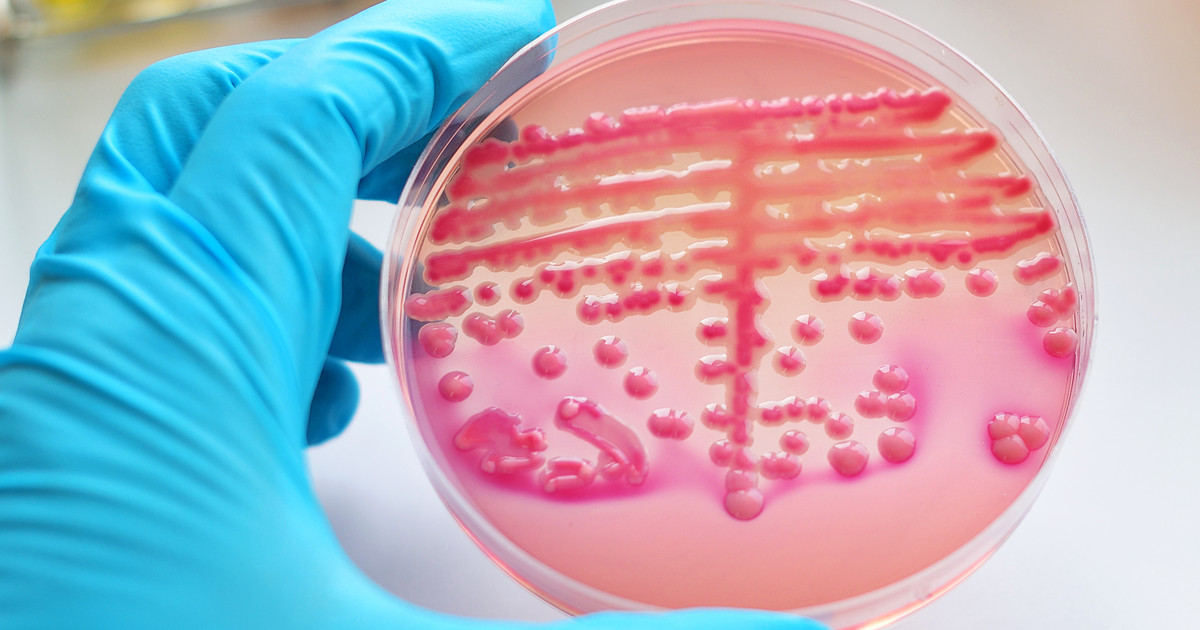

Learn About Rifampicin
Rifampicin handles serious bacterial infections. Of course, ladies, this is because it's an antibiotic! You can take a tablet or get an IV for this one. When you have active tuberculosis, you will take about 10 mg daily for every kilo you weigh. Your max dose is 600 mg daily. Ladies, expect to take this antibiotic for 6 months. You will likely take other medications at the same time as this one! Tell your doctor about any side effects that stick around, bother you, or are severe.
Ladies, this one's a strong tuberculosis treatment. That said, there are other medications for TB that you have available! This antibiotic also works as a leprosy treatment and, of course, a treatment for endocarditis too. Just remember, you have to know how it works before you take it!
How It Works
Ladies, rifampicin's an antibiotic! It's also considered an antimycobacterial medicine. Overall, this one's going to handle bacterial infections very well. It'll do it by stopping bacteria from completing RNA synthesis! This medication's going to stop the RNA transcription process. This happens when it binds to a part of the DNA-dependent RNA polymerase. Specifically, to the beta subunit! Your liver will absorb this antibiotic. And ladies, you'll get rid of it through your stool!
This medication will be at its peak concentration in 2 to 4 hours. Ladies, it comes with a half-life of 3 to 4 hours when you're healthy! Liver issues extend this. The half-life reaches up to 11 hours when you have end-stage kidney disease.
Uses
This medication treats tuberculosis. It's great at it! Of course, it's often used along with other medicines for this. Some doctors even prescribe rifampicin to prevent this condition! It has other uses too, like preventing meningitis. However, it only works when you have Neisseria meningitidis bacteria in your nose or throat. Ladies, it stops you from spreading this bacteria! This antibiotic doesn't handle the symptoms of meningitis. It does, however, help with joint infections, leprosy, and endocarditis.
Ladies, this antibiotic works on central nervous system infections too, like brain abscesses and encephalitis. It even has 'off-label' uses, like for itching from liver disease. You will even benefit from taking it for brucellosis!

Side Effects
This medication has some side effects, just like any other one! Ladies, the common ones are headaches, nausea, upset stomach, and heartburn. You're likely to see changes in your period cycle too! It also triggers color changes in your tears, pee, sweat, and saliva. Expect orange, red, or brown. These go away when you stop taking rifampicin, but the discolored teeth are usually permanent! Don't be surprised about feeling pain in your abdomen, appetite loss, diarrhea, and some changes to your coordination or behavior. These are all side effects too.
Ladies, this antibiotic often changes some lab test results. You will see shifts in liver function, red blood cell counts, and serum uric acid level tests! Your results will be lower for red blood cells and higher for the other two in most cases. Ladies, this medication can mean liver disease for some of you. That means you have to know those warning signs! They include pain in your abdomen, dark pee, jaundice, and persistent nausea. Talk to your doctor right away about all of these.
Precautions
Take precautions with this antibiotic. Ladies, be ready to go over your health history with your doctor! They need to know about everything, since rifampicin isn't safe for all of you. You often can't take it when you have a history of bleeding conditions, liver disease, or diabetes. In addition, it's not safe for you or your baby in the last few weeks of pregnancy. You're more likely to bleed! Ladies, avoid it when you're breastfeeding too. Remember to use more than one type of birth control, since this medication means hormonal birth control isn't as effective. And ladies, be ready to wear glasses rather than soft contact lenses. This antibiotic stains the latter!
This antibiotic often means problems with drug screening. Results are often inaccurate! So, ladies, talk to your doctor when you need a test like this. You will also have regular blood tests. They check for infection! Ladies, you will take this medication until your infection is gone. When you're taking it orally, you can't have food. Space your meals out so you have it one hour before or 2 hours after. However, drink a full glass of water when you do take this medication!

Medication Interactions
Rifampicin interacts with many medications. In fact, there are over 490 interactions. Ladies, 198 of these are serious ones! You need to talk to your doctor about all of your medication, even supplements, before you take this one. They're going to help you avoid these interactions. Your pharmacist can check this list over too!
Liver damage is a high risk in many of these interactions. The medications this antibiotic affects this way include those for blood pressure, cholesterol, heart problems, and depression. Even ones for arthritis do it! Ladies, OTC pain medications mean a higher risk of liver damage with this antibiotic too. Another significant effect is rifampicin speeding the removal of some medications. This includes some blood thinners, oral diabetes meds, and calcium channel blockers. Tell your doctor when you take any of them! Ladies, ways to avoid interactions include adjusted doses and medication changes.